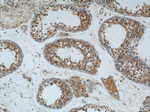
ALKBH3 Antibody in Immunohistochemistry (Paraffin) (IHC (P))

Search
Proteintech
ALKBH3 Polyclonal Antibody
{{$productOrderCtrl.translations['antibody.pdp.commerceCard.promotion.promotions']}}
{{$productOrderCtrl.translations['antibody.pdp.commerceCard.promotion.viewpromo']}}
{{$productOrderCtrl.translations['antibody.pdp.commerceCard.promotion.promocode']}}: {{promo.promoCode}} {{promo.promoTitle}} {{promo.promoDescription}}. {{$productOrderCtrl.translations['antibody.pdp.commerceCard.promotion.learnmore']}}
产品信息
12292-1-AP
种属反应
已发表种属
宿主/亚型
分类
类型
抗原
偶联物
形式
浓度
规格
纯化类型
保存液
内含物
保存条件
运输条件
产品详细信息
Immunogen sequence: MEPNPHWHP VLRTLKNRIE ENTGHTFNSL LCNLYRNEKD SVDWHSDDEP SLGRCPIIAS LSFGATRTFE MRKKPPPEEN GDYTYVERVK IPLDHGTLLI MEGATQADWQ HRVPKEYHSR EPRVNLTFRT VYPDPRGAPW (148-286 aa encoded by BC015155)
靶标信息
Dioxygenase that repairs alkylated DNA containing 1- methyladenine (1meA) and 3-methylcytosine (3meC) by oxidative demethylation. Has a strong preference for single-stranded DNA. Able to process alkylated 3mC within double-stranded regions via its interaction with ASCC3, which promotes DNA unwinding to generate single-stranded substrate needed for ALKHB3. May also act on RNA. Requires molecular oxygen, alpha-ketoglutarate and iron.
仅用于科研。不用于诊断过程。未经明确授权不得转售。
生物信息学
蛋白别名: AlkB homolog 3; alkB homolog 3, alpha-ketoglutaratedependent dioxygenase; alkB, alkylation repair homolog 3; Alkylated DNA repair protein alkB homolog 3; Alpha-ketoglutarate-dependent dioxygenase alkB homolog 3; DEPC 1; DEPC-1; FLJ43614; hABH3; m MGC118790; mAbh3; MGC118792; MGC118793; MGC134125; Prostate cancer antigen 1; prostate cancer antigen-1; RP23-375N21.4
基因别名: 1700108H04Rik; 1810020C19Rik; ABH3; ALKBH3; DEPC-1; DEPC1; hABH3; mABH3; PCA1
UniProt ID: (Human) Q96Q83, (Rat) Q5XIC8, (Mouse) Q8K1E6
Entrez Gene ID: (Human) 221120, (Rat) 362169, (Mouse) 69113